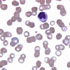

|
|
- A genus of tick-borne protozoan parasites that infests the red blood cells of mammals, including humans. There are many recognized species, and the distribution is world-wide.
(Source: National Library of Medicine 2013 MeSH Scope Note and Classification)
- Images
-

- Figure 1. Peripheral blood smear showing the ring and Maltese cross forms of Babesia.


- Figure 2. Babesia seen on Giemsa staining of the peripheral blood smear (thin smear).


- Figure 3. Babesia, on Giemsa staining of the peripheral blood smear (thin smear).

- Notes
- Figure 1 contributed by Alexander Kratz, MD, Massachusetts General Hospital, Boston, MA.
- Related Cases
- Related Images From Cases
-

- References
-
- National Library of Medicine 2013 MeSH Scope Note and Classification
|
|